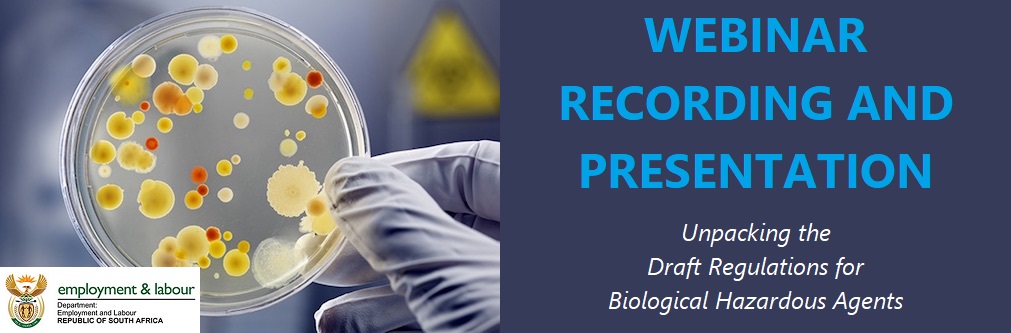

Webinar Recording and Presentation: Unpacking the Draft Regulations for Biological Hazardous Agents
Wednesday, 26 August 2020

Unpacking the Draft Regulations for
Biological Hazardous Agents
WATCH THE WEBINAR RECORDING HERE
DOWNLOAD THE PRESENTATION HERE
The Minister of Employment and Labour, has given notice that he intends, in terms of Section 43 of the Occupational Health and Safety Act, 1993 (Act No. 85 of 1993), to make regulations in the schedule.
The Minister has given 90 days, from the date of publication of this notice - 31 July 2020, to submit comments on the draft regulations.
Saiosh appointed a Technical Committee (TC) that will consider all constructive comments received in this forum. The Saiosh TC will submit a consolidated set of comments to the Department of Employment and Labour in the prescribed manner before the 90 days time period.
HAVE YOUR SAY - SUBMIT YOUR COMMENTS HERE
"Saiosh - Keeping You Informed"
|